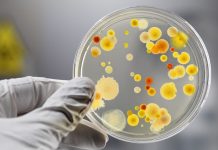
医生提醒:流感高发期,抗生素服用需谨慎(耐药性已致死3万多欧洲人)!

【医学奇迹?】一比利时人连续吃了32年薯片(条),啥事没有!...
(据VRT消息)佛拉芒-布拉班特省Schaffen...
多吃坚果少吃盐,研究:饮食习惯影响寿命长短
(早报讯) 一项最新调查显示,饮食问题造成全球每...
【食材揭秘】松露知多少?只有贵吗?
这几年来,几乎每年都会到意大利的ALBA学...
美生物学家:现代医学让你“健康恶化”
80岁的美国生物化学家弗朗西斯(Raymo...
医生提醒:流感高发期,抗生素服用需谨慎(耐药性已致死3万多欧...
研究表明,多重抗性细菌在欧洲造成33,00...
周末闲聊:比利时的秋天会让人更多愁善感吗?
秋季感伤是传说还是真的?比利时的深...
深秋的比利时,新鲜蔬果不可少
秋季蔬果的功效
当秋天来临,变化的...
【周末闲聊】为什么四分之三的比利时人不愿意看牙医?
为什么四分之三的比利时人不愿意看牙医根据保...
【周末出行】比利时百年温泉名城的一日休闲游
温泉城的休闲一日您是否知道“SPA...
汉方药走俏日本 洋中药为何逆袭中国
十年后,中国市场上最有名的中药品牌可能是日本生产的...